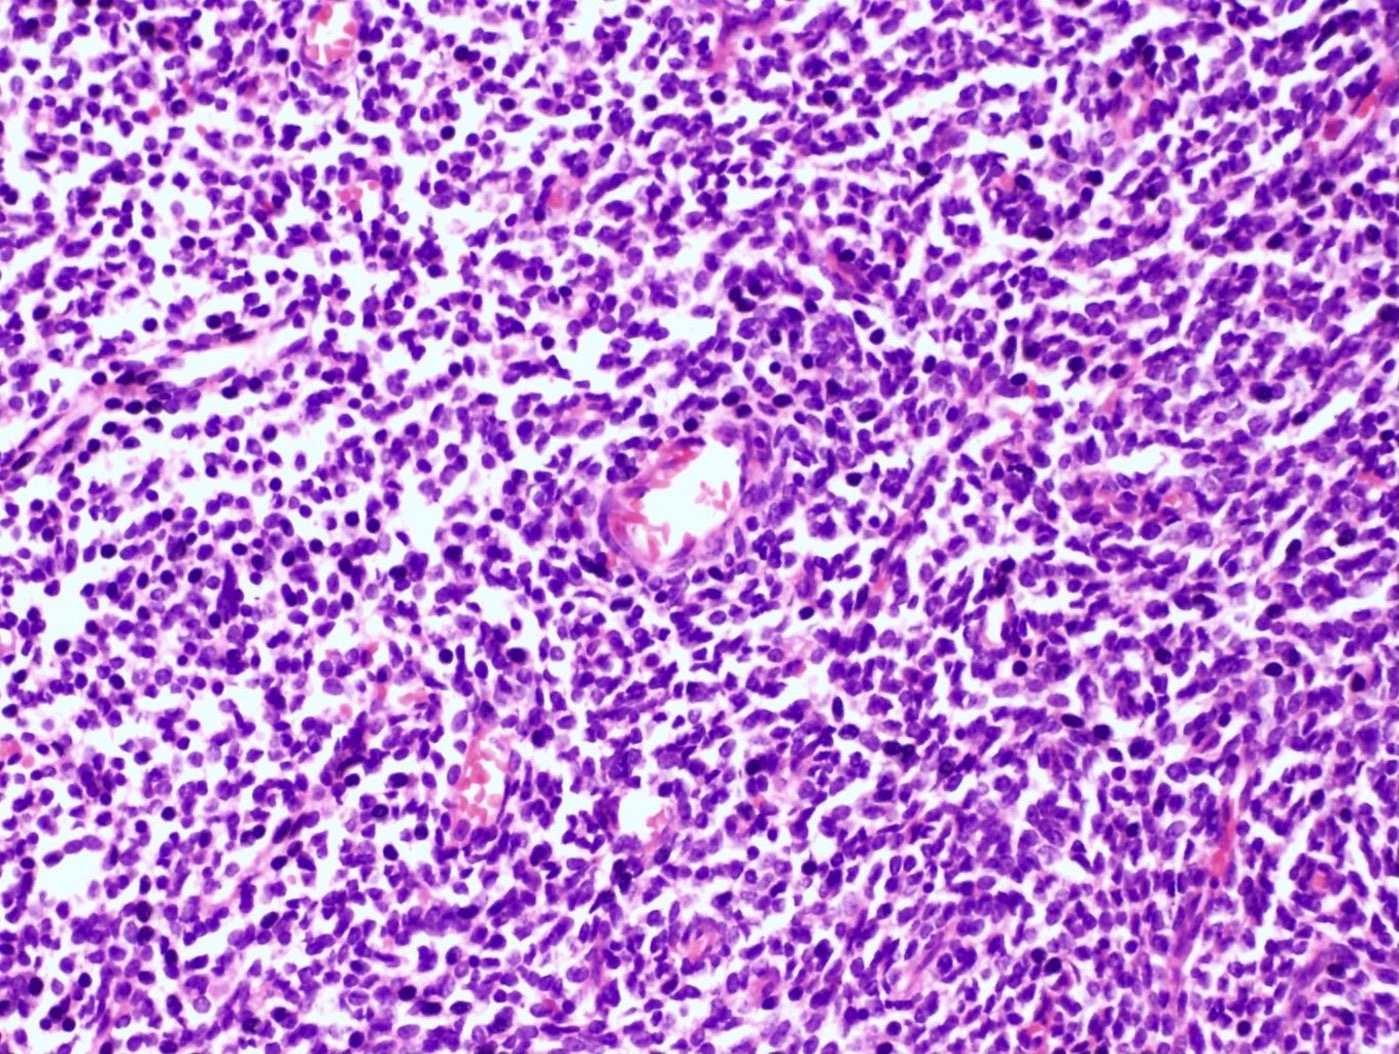

Table of Contents
Definition / general | Essential features | Terminology | ICD coding | Epidemiology | Sites | Clinical features | Diagnosis | Radiology description | Radiology images | Prognostic factors | Case reports | Treatment | Gross description | Gross images | Frozen section description | Frozen section images | Microscopic (histologic) description | Microscopic (histologic) images | Cytology description | Cytology images | Positive stains | Negative stains | Molecular / cytogenetics description | Molecular / cytogenetics images | Videos | Sample pathology report | Differential diagnosis | Practice question #1 | Practice answer #1 | Practice question #2 | Practice answer #2Cite this page: Kertowidjojo E, Ellenson LH. Low grade endometrial stromal sarcoma. PathologyOutlines.com website. https://www.pathologyoutlines.com/topic/uterusesslowgrade.html. Accessed September 28th, 2025.
Definition / general
- Malignant mesenchymal tumor comprised of cells resembling proliferative phase endometrial stroma with infiltrative growth or lymphovascular invasion
Essential features
- Histologic features include permeative tongue-like islands of tumor cells composed of monotonous oval to spindle cells with minimal cytologic atypia, often demonstrating whorling around blood vessels; smooth muscle and sex cord-like differentiation are common
- Diagnosis may require extensive sampling of the tumor myometrial interface to evaluate for invasion and exclude endometrial stromal nodule
- Recurrent rearrangements involving JAZF1 and PHF1 are common, though absence does not preclude the diagnosis
Terminology
- Endolymphatic stromal myosis
ICD coding
- ICD-O: 8931/3 - endometrial stromal sarcoma, low grade
- ICD-11: 2B5C & XH1S94 - endometrial stromal sarcoma, primary site and endometrial stromal sarcoma, low grade
Epidemiology
- Second most common uterine sarcoma (Histopathology 2009;54:355)
- Wide age range but with predilection for premenopausal and perimenopausal women (mean: 52 years, range: 16 - 83 years) (Br J Cancer 2008;99:1210)
- Risk factors: prolonged estrogen or tamoxifen use, pelvic radiation (Gynecol Oncol 1985;21:135, J Clin Pathol 1995;48:596, Cancer 1986;58:2003)
Sites
- Uterus: more commonly the corpus than the cervix
- Rarely extrauterine, usually associated with endometriosis
Clinical features
- Abnormal uterine bleeding (most common), pelvic pain, uterine mass
- Occasionally, patients present with metastases (most commonly lung, adnexal or nodal) (Adv Anat Pathol 2000;7:257)
Diagnosis
- Radiologic findings on magnetic resonance imaging (MRI) (see radiology description)
- Endometrial sampling may obtain diagnostic material in ~30%
- However, the lesion is indistinguishable from endometrial stromal nodule in a curettage specimen (Mod Pathol 2016;29 Suppl 1:S92)
Radiology description
- MRI: highest sensitivity
- Endometrial or myometrial mass, mostly solid but may display cystic degeneration (Int J Gynecol Cancer 2017;27:1877)
- Nodular worm-like intramyometrial lesions with irregular margin (Eur Radiol 2001;11:28)
- Lower apparent diffusion coefficient (ADC) value compared to T2 hyperintense leiomyoma (Cancer Imaging 2019;19:63)
- Less frequent necrosis, hemorrhage and feather-like enhancement compared to high grade endometrial stromal sarcoma (Cancer Imaging 2019;19:63)
Radiology images
Prognostic factors
- Typically indolent, with an overall 5 year survival of > 90% and a 10 year survival of 75%
- Factor affecting prognosis: stage
- Controversial factors: older age (> 50 years), mitotic index, necrosis (Oncology 2006;71:333)
- Factors of uncertain significance: tumor size, lymphovascular invasion, hormonal status, ploidy (Adv Anat Pathol 2010;17:113)
Case reports
- 42 year old woman with pelvic pain and endometriosis (Gynecol Oncol Rep 2017;21:119)
- 48 year old woman status post uterine morcellation (Case Rep Obstet Gynecol 2020;2020:7201930)
- 50 year old woman with a pancreatic mass (Diagn Pathol 2019;14:30)
Treatment
- Hysterectomy and bilateral salpingo-oophorectomy
- Higher risk of recurrence if hysterectomy alone (Int J Gynecol Cancer 2013;23:488)
- Radiation therapy may control local recurrences but does not improve overall survival (Int J Gynecol Cancer 2009;19:1232)
- Hormonal therapy (GnRH analogs, progestins and aromatase inhibitors) (Crit Rev Oncol Hematol 2008;65:129)
Gross description
- Poorly circumscribed soft yellow-tan to white nodules extending from the endometrium and invading into the myometrium
- Worm-like plugs of tumor may be seen in the myometrium or lymphovascular channels (Am J Surg Pathol 1990;14:415)
- Often with a polypoid endometrial component
- May appear deceptively well circumscribed: extensive sampling of the tumor myometrial interface is necessary to rule out endometrial stromal nodule (Int J Gynecol Pathol 2014;33:374)
- Hemorrhage and necrosis may be seen
Gross images
Contributed by Elizabeth Kertowidjojo, M.D., Ph.D., M.P.H. and Ayse Ayhan, M.D., Ph.D.
Images hosted on other servers:
Frozen section description
- Spindle to oval cells with permeative growth into the myometrium
- May be associated with a polypoid growth
- Minimal cytologic atypia and low mitotic count
- May display smooth muscle or sex cord-like differentiation
Frozen section images
Microscopic (histologic) description
- Irregular cellular islands, forming permeative tongue-like pattern of myometrial invasion with frequent vascular invasion
- Monotonous oval to spindle cells with minimal cytologic atypia, vesicular chromatin and scant cytoplasm
- Mitotic count is usually low (< 5/10 high power fields), necrosis is usually absent
- Tumor cells may whorl around delicate arteriolar type vessels, reminiscent of proliferative phase endometrial stroma
- May have admixed collagen bands / plaques and foamy histiocytes
- May have smooth muscle differentiation, particularly in a starburst morphology, with collagen bands radiating towards the periphery of the nodule
- Other reported types of differentiation: fibromyxoid / fibrous, sex cord-like, epithelioid, rhabdoid, endometrioid glands, pseudopapillae, clear cells, bizarre cells, adipose tissue (Mod Pathol 2016;29:S92)
Microscopic (histologic) images
Contributed by Elizabeth Kertowidjojo, M.D., Ph.D., M.P.H. and Ayse Ayhan, M.D., Ph.D.
Cytology description
- Resembles benign endometrial stromal cells
- Moderate to marked cellularity composed of single cells and clusters of bland cells with scant cytoplasm, small round to spindle nuclei with fine chromatin (Acta Cytol 2007;51:461)
- Interspersed delicate blood vessels may be present
- Distinction between low grade endometrial stromal sarcoma and endometrial stromal nodule cannot be made based on cytology, as it requires evaluation of the tumor myometrium interface
- Distinction between low grade endometrial stromal sarcoma and other monomorphic spindle cell neoplasm is difficult on cytology, especially without immunohistochemistry
Cytology images
Positive stains
- CD10: sensitivity 91%, specificity 45% (Int J Gynecol Pathol 2018;37:372)
- IFITM1: sensitivity 83%, specificity 70% (Int J Gynecol Pathol 2018;37:372)
- WT1, ER (40 - 100%), PR (69 - 100%)
- Keratins: AE1 / AE3, CAM5.2, MNF 116, CK8 / 18
- Smooth muscle markers (SMA, desmin, caldesmon) often positive in areas of smooth muscle differentiation
- Sex cord markers (inhibin, calretinin, CD99, MelanA, WT1) may be positive in areas of sex cord differentiation
- Beta catenin: nuclear staining without associated mutation (Mod Pathol 2008;21:756)
Negative stains
Molecular / cytogenetics description
- Most common: JAZF1-SUZ12 t(7;17)(p15;q21) fusion (50%)
- Other translocations: JAZF1-PHF1 t(6;7)(p21;p15) in 6% of cases, EPC1-PHF1 t(10;17)(q22;p13) in 4%, MEAF6-PHF1 t(1;6)(p34;p21) in 3% and MBTD1-Cxorf67 t(X;17)(p11.2;q21.33) in 2% (Am J Surg Pathol 2011;35:1364, Genes Chromosomes Cancer 2016;55:834)
Molecular / cytogenetics images
Videos
Endometrial stromal sarcoma
Uterine mesenchymal neoplasms
Sample pathology report
- Uterus, hysterectomy:
- Endometrial stromal sarcoma, low grade (see synoptic report)
- Tumor size: 9 cm
- Lymphovascular invasion identified
- Surgical margins uninvolved
Differential diagnosis
- Endometrial stromal nodule:
- Absent to minimal myometrial invasion (≤ 3 protrusions, each measuring < 3 mm) and no lymphovascular invasion
- High grade endometrial stromal sarcoma:
- Cellular leiomyoma:
- Fascicular growth, large thick walled blood vessels, cleft-like spaces
- Lack JAZF1 or PHF1 fusions
- Leiomyosarcoma:
- Marked cytologic atypia, mitotic activity and necrosis
- Large thick walled blood vessels
- Lack JAZF1 or PHF1 fusions
- Uterine tumor resembling ovarian sex cord tumor:
- Absence of any conventional endometrial stromal component
- ESR1 or GREB1 fusions in a subset
- Endometrial polyp:
- No expansile growth or displacement of adjacent endometrium
- Gland poor adenomyosis:
- No confluent growth or displacement of myometrium
Practice question #1
Practice answer #1
D. Low grade endometrial stromal sarcoma. The tumor shows a polypoid component, as well as a characteristic permeative tongue-like invasion pattern seen on low power. The presence of invasion rules out an endometrial stromal nodule (answer B) and cellular leiomyoma (answer A). The lack of any glandular component rules out endometrioid carcinoma (answer C). While low grade endometrial stromal sarcoma can have sex cord-like differentiation, the presence of conventional low grade endometrial stromal sarcoma rules out uterine tumor resembling ovarian sex cord tumor (answer E).
Comment Here
Reference: Low grade endometrial stromal sarcoma
Comment Here
Reference: Low grade endometrial stromal sarcoma
Practice question #2
Which of the following can reliably diagnose low grade endometrial stromal sarcoma?
- Endometrial biopsy
- Hysterectomy
- Myomectomy
- Presenting symptoms and clinical history
- Ultrasound
Practice answer #2
B. Hysterectomy. The presenting symptoms and clinical findings in low grade endometrial stromal sarcoma are nonspecific, including abnormal uterine bleeding, pelvic pain and uterine mass. While ultrasound can detect a uterine mass, distinguishing low grade endometrial stromal sarcoma from other entities such as endometrial stromal nodule and leiomyoma can be difficult. While biopsy and myomectomy may obtain diagnostic material, low grade endometrial stromal sarcoma is distinguished from endometrial stromal nodule by its invasive growth pattern, which cannot be appreciated on limited sampling.
Comment Here
Reference: Low grade endometrial stromal sarcoma
Comment Here
Reference: Low grade endometrial stromal sarcoma